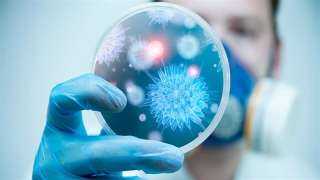

خطة وزارة التعليم لمواجهة الأمراض المعدية: تطعيمات مدرسية وتوعية صحية
أصدرت الوزارة منشور الأمن رقم (7) لسنة 2025 بشأن تفعيل الإجراءات الوقائية داخل جميع المنشآت التعليمية، ورفع درجة الاستعداد القصوى لمواجهة انتشار الأمراض المعدية والفيروسات التنفسية، وذلك في ضوء حرص وزارة التربية والتعليم والتعليم الفني على الحفاظ على صحة وسلامة الطلاب والعاملين بالمنظومة التعليمية.
ووجّهت الوزارة، في المنشور، جميع المديريات والإدارات والمدارس بالتنسيق المكثف مع وزارة الصحة والسكان وكافة الجهات المعنية، لمتابعة الحالة الصحية داخل المدارس على مدار اليوم، خاصة في ظل التقارير العالمية التي أشارت إلى ظهور إصابات بفيروس "الميتانيمو" في بعض الدول، وهو أحد الفيروسات التنفسية المسببة لأعراض شبيهة بالأنفلونزا.
وأكدت الوزارة على ضرورة التطبيق الصارم لكافة الاشتراطات الوقائية، واتخاذ إجراءات سريعة للتعامل مع أية حالات اشتباه، بما يضمن استمرار العملية التعليمية في بيئة آمنة وصحية.
تعليمات مواجهة الأمراض المعدية والفيروسات في المدارس
وشملت التعليمات الصادرة عن الوزارة ما يلي:
إعداد خطة وقائية داخل كل مدرسة للتعامل مع حالات الاشتباه أو الطوارئ الصحية.
التشديد على النظافة العامة والتهوية الجيدة في الفصول ودورات المياه.
التأكد من توافر المياه الجارية والصابون داخل المدارس بشكل يومي.
تطبيق خطة التطعيمات المدرسية ضد الالتهاب السحائي والثنائي للفئات المستهدفة.
متابعة الحالة الصحية للطلاب يوميًا، مع إجراء كشف فوري على الحالات المشتبه بها.
تنظيم ندوات ولقاءات توعوية للطلاب والعاملين حول الوقاية من الأمراض المعدية.
التأكيد على سلامة الأغذية والوجبات المدرسية، وتشديد الرقابة الصحية على العاملين بها.
تخصيص متابعة خاصة للطلاب المصابين بأمراض مزمنة، واتخاذ الإجراءات الطبية المناسبة فور ظهور أي أعراض.
وأوضحت الوزارة أن هذه التوجيهات تأتي في إطار مسؤوليتها المشتركة مع الجهات الصحية لضمان الاستعداد الكامل لأي طارئ صحي، مشددة على دور مديري المدارس والزائرات الصحيات في تنفيذ التعليمات بدقة.